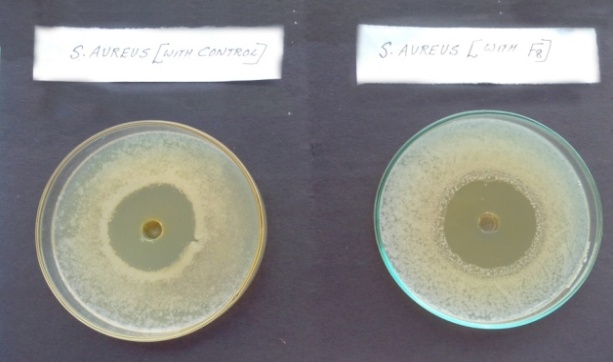

Department of Pharmaceutics, Nirmala College of Pharmacy Muvattupuzha Ernakulam, Kerala, India.
Email: vcvineetha@gmail.com
Received: 17 Oct 2014 Revised and Accepted: 08 Nov 2014
ABSTRACT
Objective: The present study aims at the development and evaluation of controlled release dental films containing metronidazole in a carrier which consists of a common non-biodegradable polymer and various co-polymers in different concentrations for targeted delivery of drug and thus prolonging the action.
Methods: Solvent casting method is adopted. Nine formulations were prepared with ethyl cellulose as the main polymer and co-polymers like PVPK30, HPMC K4M, Eudragit RS 100 in 3 concentrations (10, 20, 30%w/w of ethyl cellulose). Ethyl cellulose and co-polymers were dissolved in the solvent system, containing ethanol, chloroform and dichloromethane. Drug was dissolved in this mixture and mixed homogeneously and films were casted. These films were evaluated for thickness & content uniformity, swelling index, percentage moisture loss, in vitro drug release studies.
Results: The best film was selected as the one which is prepared with ethyl cellulose and eudragitRS100 (20%w/w of ethyl cellulose) ie F8 since it can release the drug above MIC in each day of treatment and having sufficient drug content and other required characteristics. This formulation undergoes zero order release kinetics and non-Fickian diffusion mechanism.
Conclusion: Ethyl cellulose - eudragit RS100 (20%w/w of EC) combination is the best carrier among the others for the preparation of metronidazole dental film for prolonging the drug action up to 10 days.
Keywords: Metronidazole, Dental film, Periodontitis, Eudragit RS100, Local delivery.
INTRODUCTION
Oral cavity provides a diverse environment for colonization of a wide range of microorganisms. Periodontal diseases are a general term encompassing several pathological conditions such as gingivitis and periodontitis. Periodontitis is a local infection with primary bacterial etiology in the gingival crevices, which affects the structural organs surrounding the teeth like periodontal ligament, connective tissue and bone. The warm and moist pocket environment fosters the growth of gram-negative, anaerobic bacteria that proliferate in the sub gingival space. Approximately 70 million people suffer from adult periodontitis. The aim of dental healthcare is to control the population of microorganisms. Slowing or arresting of the oro-dental infections can be achieved by controlling bacterial plaque. The systemic administration of antibiotics is a useful method for controlling sub gingival flora but it has been found that discontinuation of systemic antibiotic therapy results in re-colonization of pathogens. Therefore long term antimicrobial therapy is required for complete eradication of microorganisms. High oral doses are required to achieve effective concentrations in the pocket but high doses given for long periods of time eventually causes development of resistant strains of bacteria, super infection, gastrointestinal and central nervous system disturbances. To overcome the disadvantages of systemic chemotherapy with antibiotics, recent technical advancements have led to the development of new drug delivery systems that provide controlled therapeutic activity by targeting the delivery of a drug to a particular site. If a particular drug is targeted to a desired site, it minimizes the distribution of drug to other body organs. Controlled drug delivery systems offer numerous advantages compared with conventional dosage forms [1, 2]. In the form of films, we can directly place the drug in to the cavity and thus reduce the impact of antibacterial agent on other non oral body parts.
Periodontal films are Matrix delivery system from which the drug is released either through diffusion or matrix dissolution and is applied to a periodontal pocket or paradentium for the purpose of treating periodontal diseases. The pharmaceutical composition, which is provided in the form of gel, sheet, film or bar-like formulation, releases a controlled and effective amount of an active ingredient at the periodontal pocket [11]. Films which comprise polymers and active ingredients for treatment of periodontal diseases have been developed. These films are said useful for the treatment of plaques and inflammation beneath the gingival margin. These can be applied directly to the lesional region to be treated, and therefore, the active ingredient can be concentrated to the desired site selectively. This modified therapeutic method has been proved to be more effective than any conventional pharmacotherapy. The most suitable forming process among others is selected depending on the physico-chemical properties of the polymers employed [9, 14]. By using various co-polymers along with the ethyl cellulose, the drug release can be extended for a prolonged period.
The convenient size of the film or sheet may be 0.1-0.5 mm in thickness, 0.5-3 mm in width, and 5-50 mm in length. Furthermore, the composition may be cut in suitable size by the user depending on several factors, such as severity of the disease, and the width and depth of the locus to be applied [12]. The composition can be applied to the periodontal pocket or paradentium by insertion. Once a film is placed in periodontal cavity, the polymer swells, expands, and reaches narrow crevices and furcations of the cavity, carrying active agent throughout the cavity. This provides most desirable efficacy at treatment site [10].
The primary objective of this research was to design and evaluate controlled release dental films containing Metronidazole for placement into the periodontal pockets of periodontitis patients for targeted delivery of the drug in order to reduce periodontal pathogens. The effects of various formulation variables on the drug release profiles from the films were studied to determine optimum formulation.
Metronidazole is a nitro-imidazole, used to treat protozoal infections. It is bactericidal to anaerobic organisms and is believed to disrupt bacterial DNA synthesis. Metronidazole is effective against anaerobes such as Porphyromonas gingivalis and Prevotella intermedia. The dose recommended for the treatment of anaerobic infection is 500 mg oral; i. v every 6-8 hours for seven days. Systemic treatment for periodontitis by the oral route using oral tablets requires a total of about 5250 to 7000 mg of metronidazole. However, non-systemic treatment for periodontitis with the slow release composition uses only about 2.4 mg per periodontal pocket. As patients with the most advanced cases of periodontitis may have about 20 diseased pockets, and if the metronidazole films are placed in each of these pockets, then the total dosage of metronidazole would be about 50 mg. This total dosage is less than 1% of the total systemic (oral) dose and reflects a substantial safety factor over systemic treatment with oral metronidazole [3].
MATERIALS AND METHODS
Metronidazole was obtained from Research Labfine Chem Industries, Mumbai, India, Ethyl cellulose and Poly vinyl pyrrolidine K30(PVPK30) were obtained from Otto chemie pvt. Ltd, Cochin, hydroxy propyl methylcellulose K4M (HPMCK4M) was obtained from Rolex Chemical Industries (Mumbai, India), and Eudragit RS-100 was obtained from Rohm-pharm, Germany. Polyethylene glycol (PEG)-400, dibutyl pthalate was purchased from Loba Chemie, Mumbai. Chloroform was purchased from Nice chemicals Pvt. Ltd, Dichloromethane was purchased from spectrum reagents & chemicals pvt ltd, Mumbai; Ethanol was purchased from Nice chemicals, Cochin. Other materials used in the study were of analytical grade and UV spectrometer (Shimadzu 2401/PC Japan) was used for analytical purpose.
Preformulation studies
Preformulation study of the drug was carried out to establish its identity and purity which includes λmax of the drug. An absorption maximum of metronidazole was determined using 0.1 N HCl Solution ranging from 1-20 μg/ml were scanned from 200-400 nm using UV spectrophotometer [6].
FTIR Studies
Compatibility of metronidazole with the excipient was established by Infrared Absorption Spectral Analysis (FTIR). Any changes in the chemical composition after combining with the excipient were investigated with IR spectral analysis.
Preparation of films containing metronidazole
Periodontal films were prepared by solvent casting technique. Glass moulds were used for casting of the films. Formulations were designed as showed in the Table‐1, in which Ethylcellulose was taken as the main nonbiodegradable polymer in combination with different co‐polymers of different concentrations for each cast films. Films were prepared by dissolving Ethylcellulose and copolymers (PVP K‐30, HPMC K4M, and Eudrajit RS-100) in chloroform, dichloromethane & alcohol (1:1:0.5) solution, using dibutyl phthalate and PEG‐400 as plasticizers. Metronidazole was added to the polymeric solution and mixed homogenously using magnetic stirrer in a closed beaker. After complete mixing, it kept for 15 minutes in closed condition to remove the entrapped air bubbles. 10 ml of the solution was poured into the clean leveled glass moulds of 9 cm2. The solvent was allowed to evaporate slowly by inverting a glass funnel with a cotton plug closed into the stem of the funnel at room temperature for 24 hours. After complete evaporation of solvent, cast films were obtained, which were then cut into pieces, wrapped in an aluminum foil and stored in a desicator at room temperature in a dark place for further evaluation studies.
Table 1: It shows formulae used for the development of Metronidazole dental films
Ingredients |
Formulation code |
||||||||
F1 |
F2 |
F3 |
F4 |
F5 |
F6 |
F7 |
F8 |
F9 |
|
Metronidazole(mg) |
120 |
120 |
120 |
120 |
120 |
120 |
120 |
120 |
120 |
Ethyl cellulose(mg) |
500 |
500 |
500 |
500 |
500 |
500 |
500 |
500 |
500 |
Poly vinyl pyrrolidine K30(%w/w of EC) |
10 |
20 |
30 |
- |
- |
- |
- |
- |
- |
Hydroxy propyl methyl cellulose K4M((%w/w of EC) |
- |
- |
- |
10 |
20 |
30 |
- |
- |
- |
Eudragit RS-100(%w/w of EC) |
- |
- |
- |
- |
- |
- |
10 |
20 |
30 |
Poly ethylene glycol: Dibutyl phthalate |
1:1 |
1:1 |
1:1 |
1:1 |
1:1 |
1:1 |
1:1 |
1:1 |
1:1 |
Chloroform: |
1:1 |
1:1 |
1:1 |
1:1 |
1:1 |
1:1 |
1:1 |
1:1 |
1:1 |
Alcohol(ml) |
4 |
4 |
4 |
4 |
4 |
4 |
4 |
4 |
4 |
Characterization of the films
Formulated films were subjected to the preliminary evaluation tests. Films with any imperfections, entrapped air, or differing in thickness, weight (or) content uniformity were excluded from further studies. Physicochemical properties such as thickness, weight uniformity, and percentage moisture loss, folding endurance, surface pH, swelling index and drug content uniformity of the prepared films were determined [4, 5].
Thickness uniformity
The thickness of each film was measured using the screw gauge at different positions of the film and the average was calculated [5].
Uniformity of weight
Film pieces (size of 7*2 mm) were taken from different areas of film. The weight variation of each film was calculated [3, 5, 6].
Estimation of percentage moisture loss
6 films of different concentrations of size (7 × 2 mm) were weighed accurately and then they were kept in desiccators for 3 consecutive days and then reweighed [5]. % moisture loss was calculated by formula: Moisture loss = (initial wt – final wt / initial wt) ×100.
Folding endurance studies
The folding endurance of the films was determined by repeatedly folding one film at the same place till it broke or folded up to 350 times, which is considered satisfactory to reveal good film properties. The film was folded number of times at the same place without breaking gave the value of the folding endurance. This test was done on all the films for six times [5, 6].
Surface pH
The surface pH of the films was determined in order to investigate the possible side effects due to change in pH in vivo, since an acidic or alkaline pH may cause irritation to the periodontal mucosa. The film to be tested was placed in a Petri dish and was moistened with 0.5 ml of pH 6.6 phosphate buffer and kept for 1 h. The pH was noted after bringing the electrode of the pH meter in contact with the surface of the formulation and allowing equilibrating for 1 min[4, 5].
Swelling index
The studies for Swelling Index of the films were conducted in simulated salivary fluid of pH 6.6. The film sample (1×1 cm2) was weighed and placed in a pre-weighed stainless steel wire sieve. The mesh containing the film sample was then submerged into 15 ml of the simulated salivary medium contained in a porcelain dish. At definite time intervals, the stainless steel mesh was removed, excess moisture removed by carefully wiping with absorbent tissue and reweighed [5]. Increase in weight of the film was determined at each time interval until a constant weight was observed. The degree of swelling was calculated using the formula:
S. I = (wt – w0) / w0
Where S. I is the Swelling Index, wt is the weight of film at time t and w0 is the weight of the film at time 0.
Drug content uniformity
The drug-loaded films of known weight (7 × 2 mm) were dissolved in 10 ml of ethanol.1 ml of this was made up to 10 ml with 0.1N Hcl and absorbance was measured at 276 nm[6, 13]
In vitro drug release studies
The pH of gingival fluid lies between 6.5 – 6.8, so phosphate buffer pH 6.6 was used as simulated gingival fluid. Also, since the film should be immobile in the periodontal pocket, a static dissolution model was adopted for the dissolution studies. Sets of six films of known weight and dimension were placed separately in small sealed 1 ml test tubes containing 1.0 ml of phosphate buffer (pH 6.6) and kept at 37 ± 0.5 °C for 24 h. The buffer was then drained off and replaced with a fresh 1.0 ml of buffer. The concentration of the drug was determined by UV/VIS spectrophotometer (Shimadzu) at 276 nm after suitable dilution with 0.1N HCl. [4-7] The procedure was continued for 10 consecutive days for different polymers with different concentrations.
Mass balance study
Following the in-vitro release studies, the test films were further analyzed for the drug content left in the film. Each film was dissolved in ethanol and diluted suitably with 0.1N HCl. The absorbance was measured at 276 nm. The amount of drug released into the dissolution medium and the residual content in the films were accounted and compared for the actual drug content [5, 6].
Kinetic data analysis and drug release models
To analyze the drug release rate kinetics and mechanism of drug release from the dental films, the In vitro drug release studies data was fitted into Zero order, First order, Hixson-Crowell Cube Root Law model, Higuchi model, and Korsmeyer peppas models. From these, best-fit models were selected [8].
Scanning electron microscopy (SEM)
A Scanning electron microscope (model JFC-1100 E, Jeol, Japan) was used to study the surface characteristics of the optimized filmF8 before and after dissolution. Samples (7*2 mm) were mounted on the SEM sample stab using a double sided sticking tape. The samples were coated with gold (200 A0) under reduced pressure (0.001 torr) for 2 min using an ion sputtering device (model JFC-1100 E, Jeol, Japan). The gold coated samples were observed under the SEM at room temperature and photomicrographs of suitable magnifications were obtained [5, 15].
In vitro antibacterial studies
80 ml of nutrient agar media was prepared and sterilized at 15 lb pressure for 20 min in an autoclave. Under aseptic condition 20 ml of nutrient agar media was transferred into 4 sterile petri plates. After solidification 0.1 ml of microbial suspension of both E. coli & S. aureus of known concentration was spread on the media. Wells were prepared by using a sterile borer of diameter 6 mm and the samples were added in each well separately. The optimized film F8 and the standard drug solution sample were tested. The plates were then incubated at 370C for 48 hrs. Then the zone of inhibition was measured & compared [8].
Stability studies
The stability of the entire drug loaded polymer films were studied at different temperatures using the reported procedure. The films of size (7 × 2 mm) were weighed in three sets (18 films in each set). The films were wrapped individually in aluminium foil and also in butter paper and placed in Petri dishes. These containers were stored at different temperatures like 27 ± 2°C, 5–8 ±2°C, 40±20 C for a period of 30 days. All the polymeric films were observed for any physical changes, such as color, appearance, flexibility, or texture, and the drug content was estimated at an interval of 10 days [7].
RESULTS AND DISCUSSION
To confirm the identity, purity and suitability of drug for formulation and to establish a drug profile, preformulation studies were undertaken.
λmax of the drug
The λmax of the drug was found to be 276 nm and it was in accordance with the official standard.
FTIR study
FTIR spectra of metronidazole alone and its combination with polymers are shown in fig. 1-4. From the spectra confirmed the absence of any chemical incompatibility between the drug and the polymer.
Evaluation of the prepared films
Thickness of the Films
The thickness of each film was measured at 6 different points and the average thickness with Standard deviation was calculated. The thickness of various films is given in table2. The data of films thickness indicated that there was no much difference in the thickness within the formulations.

Fig. 1: It shows FTIR Spectrum of Metronidazole

Fig. 2: It shows FTIR Spectrum of Metronidazole: HPMCK4M physical mixture

Fig. 3: It shows FTIR Spectrum of Metronidazole: Eudragit RS100 physical mixture

Fig. 4: It shows FTIR Spectrum of Metronidazole: Ethyl cellulose physical mixture
Weight uniformity test
Drug loaded films (7*2 mm) were tested for uniformity of weight and the results of weight uniformity are given in table2. Lesser standard deviation values indicated that the films were uniform in weight.
Percentage moisture loss
Moisture loss studies were conducted on all the formulations and reported in table2. It was observed that formulation F3 showed maximum amount of moisture loss because of more concentration of PVP K30 undergoing moisture loss in dry condition. Formulation F8 showed minimum percentage moisture loss because of hydrophobic eudragit RS 100.
Folding endurance
The folding endurance value for all films was > 200; it indicates that all formulations had ideal film properties.
Surface pH
Surface pH of all the formulations was determined as described in the methodology chapter. All the formulations were found to have pH between 6 –7. This reveals that the prepared films would not alter the pH of the gingival fluid in the periodontal pocket and therefore may not cause any irritation.
Swelling index
Swelling index of all films was calculated and it was in the range of17.3%-33.8%. Formulations containing eudragit RS 100 shows maximum swelling property than the other films. As the concentration of polymer increased, swelling index also increased. Swelling is very essential before the drug is released from the dosage form.
Drug content uniformity
The percentage drug content in various formulations ranged from 73.37 % – 85.08 % given in table2. It was observed from the drug content data that there was no significant difference in the uniformity of the drug content. However, when compared with the theoretical drug content the estimated drug content was slightly less; it may be due to the drug loss during fabrication of the films. The percentage of drug content in the formulations ranked in the order F8>F9>F5>F3>F2>F6>F1>F4>F7.
Mass balance study
This shows how much amount of drug remains in the film after 10days of release. The values obtained from the in vitro release studies and mass balance studies indicated that the drug content did not that much differs from the experimental drug content.
In vitro drug release studies
The In vitro drug release studies showed % drug release of 51.67% to 78.37% up to 10 days and ranked in the order F8 > F5 >F6>F2 > F7>F3>F4>F1>F9. The release time profile of various metronidazole dental films is shown in fig. 5-8.
In vitro antibacterial study
In vitro antibacterial activity was performed as mentioned in methodology on S. aureus and E. coli organisms. The results of antibacterial activity were shown in table3 and in fig. 9&10. The study indicates that the formulated polymeric film F8 containing metronidazole retained their antibacterial activity and also it shows the same effect as the standard metronidazole drug.
Table 2: It shows various physico-chemical properties of metronidazole dental films
Film code |
Mean±S. D* |
|||||||
Thickness |
Weight |
Folding |
Surface pH |
Swelling |
%Moisture |
Drug content |
Mass bal. |
|
F1 |
0.068 ± 0.004 |
0.75 ± 0.050 |
221.4±0.12 |
6.12±0.012 |
17.3±0.43 |
14.01± 0.040 |
73.37±0.42 |
17.28±0.24 |
F2 |
0.094 ± 0.009 |
0.87 ± 0.170 |
218.0±0.23 |
6.29±0.027 |
20.6±0.21 |
13.2 ± 0.037 |
75.4±0.34 |
9.82±0.21 |
F3 |
0.069± 0.006 |
1.07 ± 0.210 |
249.7±0.18 |
6.00±0.023 |
22.1±0.32 |
14.1± 0.061 |
76.8±0.31 |
12.14±0.54 |
F4 |
0.072 ± 0.007 |
0.99 ± 0.129 |
231.5±0.44 |
6.51±0.130 |
18.2±0.16 |
12.6 ± 0.031 |
73.1±0.57 |
13.09±0.32 |
F5 |
0.113 ± 0.004 |
2.16 ± 0.102 |
230.6±0.28 |
6.48±0.072 |
23.2±0.19 |
8.3 ± 0.042 |
79.2±0.23 |
6.49±0.23 |
F6 |
0.126 ± 0.002 |
2.18 ± 0.204 |
252.0±0.12 |
6.70±0.120 |
26.4±0.53 |
9.04 ± 0.065 |
74.4±0.26 |
4.10±0.22 |
F7 |
0.085 ± 0.004 |
0.95 ± 0.210 |
254.0±0.32 |
6.90±0.043 |
28.6±0.33 |
10.3 ± 0.051 |
72.5±0.41 |
8.21±0.31 |
F8 |
0.116±0.002 |
1.56 ± 0.211 |
281.0±0.26 |
6.70±0.110 |
30.7±0.25 |
7.5 ± 0.022 |
85.08±0.27 |
6.01±0.28 |
F9 |
0.128±0.008 |
2.06±0.198 |
287.8±0.31 |
6.35±0.140 |
33.8±0.35 |
9.3±.064 |
80.6±0.25 |
28.18±0.23 |
*Standard Deviation Each value is an average of 6 determinations

Fig. 5: It shows % cumulative drug release of metronidazole dental films containing PVP K30 (F1-F3)

Fig. 6: It shows % Cumulative drug release of metronidazole dental films containing HPMCK4M (F4-F6)

Fig. 7: It shows % cumulative drug release of Metronidazole dental films containing Eudragit RS100 (F7-F9)

Fig. 8: It shows comparison of % cumulative drug release of 3 formulations with high drug release (F2, F5, F8)
Fig. 9: It shows Antibacterial zone with S. aureus (With control and F8)

Fig. 10: It shows Antibacterial zone with E. coli (With control and F8)
Table 3: It shows zone of Inhibition using E. coli and S. aureus
| Organism | Sample | Zone of inhibition(mm) |
| E. coli | Pure drug | 18 |
| Dental film F8 | 16 | |
| S. aureus | Pure drug | 33 |
| Dental filmF8 | 32 |

Fig. 11: It shows the scanning electron microscopy (SEM) Images of dental film F8 before drug release study
Scanning electron microscopy (SEM)
Scanning electron micrographs indicate that prior to drug release, the top surface of the films is smooth which exhibits pores as can be seen in fig. 11. These pores indicated that the film F8 had sufficient drug loading capacity. After the release of the drug, the surface became more rough and irregular as can be seen in Figure12. The reason for this is the coagulation of polymers after the release of the drug from the pores.
Stability studies
The selected formulation was subjected to stability testing. Changes in the appearance, surface pH, folding endurance, and drug content of the stored films were investigated at a period of 10 days and after 1 month. The folding endurance and drug content of the formulation were found to be decreasing but there was no much deviation from the original value. The results at different temperatures are shown in tables 4, 5&6.
From the stability studies it was confirmed that the optimized film F8 of metronidazole remained stable at various temperatures.

Fig. 12: It shows scanning electron microscopy (SEM) Images of dental film F8 after drug release study
Table 4: It shows Stability study data at 40±20C
| Time(days) | Physical appearance | Folding endurance | Surface pH | % Drug content |
| 0 | No changes | 281±0.260 | No change | 85.08±0.270 |
| 10 | No changes | 270±0.003 | No change | 82.10±0.221 |
| 20 | No changes | 263±0.120 | No change | 80.023±0.112 |
| 30 | No changes | 253±0.321 | No change | 79.2±0.23 |
Each reading is an average of 6 determinations
Table 5: It shows stability study data at 27±20C
| Time(days) | Physical appearance | Folding endurance | Surface pH | % Drug content |
| 0 | No changes | 281±0.260 | No change | 85.08±0.270 |
| 10 | No changes | No change | No change | No change |
| 20 | No changes | No change | No change | No change |
| 30 | No changes | No change | No change | No change |
Each reading is an average of 6 determinations
Table 6: It shows stability study data at 5-8±20C
| Time(days) | Physical appearance | Folding endurance | Surface pH | % Drug content |
| 0 | No changes | 281±0.260 | No change | 85.08±0.270 |
| 10 | No changes | 275±0.270 | No change | 81.45±0.351 |
| 20 | No changes | 269±0.450 | No change | 78.82±0.423 |
| 30 | No changes | 249±0.365 | No change | 78.03±0.350 |
Each reading is an average of 6 determinations
The kinetic data analysis of optimized formulation F8 showed that the drug release from film best fits to Higuchi model, where as drug release kinetics from dental film fits to Zero order release kinetics. From Korsmeyer-peppas plot, it was concluded that the mechanism of drug release from the film followed Anomalous (non-Fickian) Diffusion.
DISCUSSION
Metronidazole dental films were prepared by solvent casting technique using ethyl cellulose as the main polymer and various copolymers in different ratios. FTIR studies confirmed the absence of chemical interaction between the drug and the polymers. The physicochemical evaluation data indicates that all films have uniform thickness and weight. Surface pH of the all the formulations was very close to the mucosal pH, indicated negligible irritation to the mucosal membrane as evident from the pH of formulations. The percentage moisture loss is very low in case of films made with eudragit RS100 because of its hydrophobic character. The folding endurance was found to be greater than 200 which indicate formation of good films. The drug content studies showed uniform and homogeneous distribution of drug into the films. The In vitro drug release studies of F8 showed slow and controlled release of the drug above MIC level for 10 days. Since the film remains immobile in the periodontal pocket, a static dissolution model was adopted in this work. The release profile exhibited rapid initial release of the drug on day one, due to initial burst effect, because of elution of the drugs from the outer surface and cut edges of the matrix. Once the burst effect was completed, slow and controlled release was seen up to ten days for F8 film and the percentage cumulative drug release was also greater in F8 formulations. Mass balance studies indicated that, the drug content did not that much differ from the experimental drug content. Film F8 confirmed good anti bacterial activity against E. coli and S. aureus. The SEM study before drug dissolution indicated that the upper surface of the film F8 contains pores inside and was loosely arranged. Because of this it has high drug loading capacity and after study indicated its release capability. Stability studies revealed that film F8 was stable at different temperatures. The kinetic data analysis of optimized formulation F8 showed that the drug release from film best fits to Higuchi model, where as drug release kinetics from dental film fits to Zero order release kinetics. From Korsmeyer-peppas plot, it was concluded that the mechanism of drug release from the film followed Anomalous (non-Fickian) Diffusion.
CONCLUSION
The above results confirm the benefits of using metronidazole for the treatment of periodontitis in the form of films made up of ethyl cellulose as the main non- biodegradable polymer and eudragit RS100 as the copolymer in an optimized concentration for controlling the rate of release of the drug above MIC for 10 days. The drug remained intact and stable in the periodontal films during storage, with no significant chemical interaction between the drug and the excipients.
CONFLICT OF INTERESTS
Declared None
REFERENCES